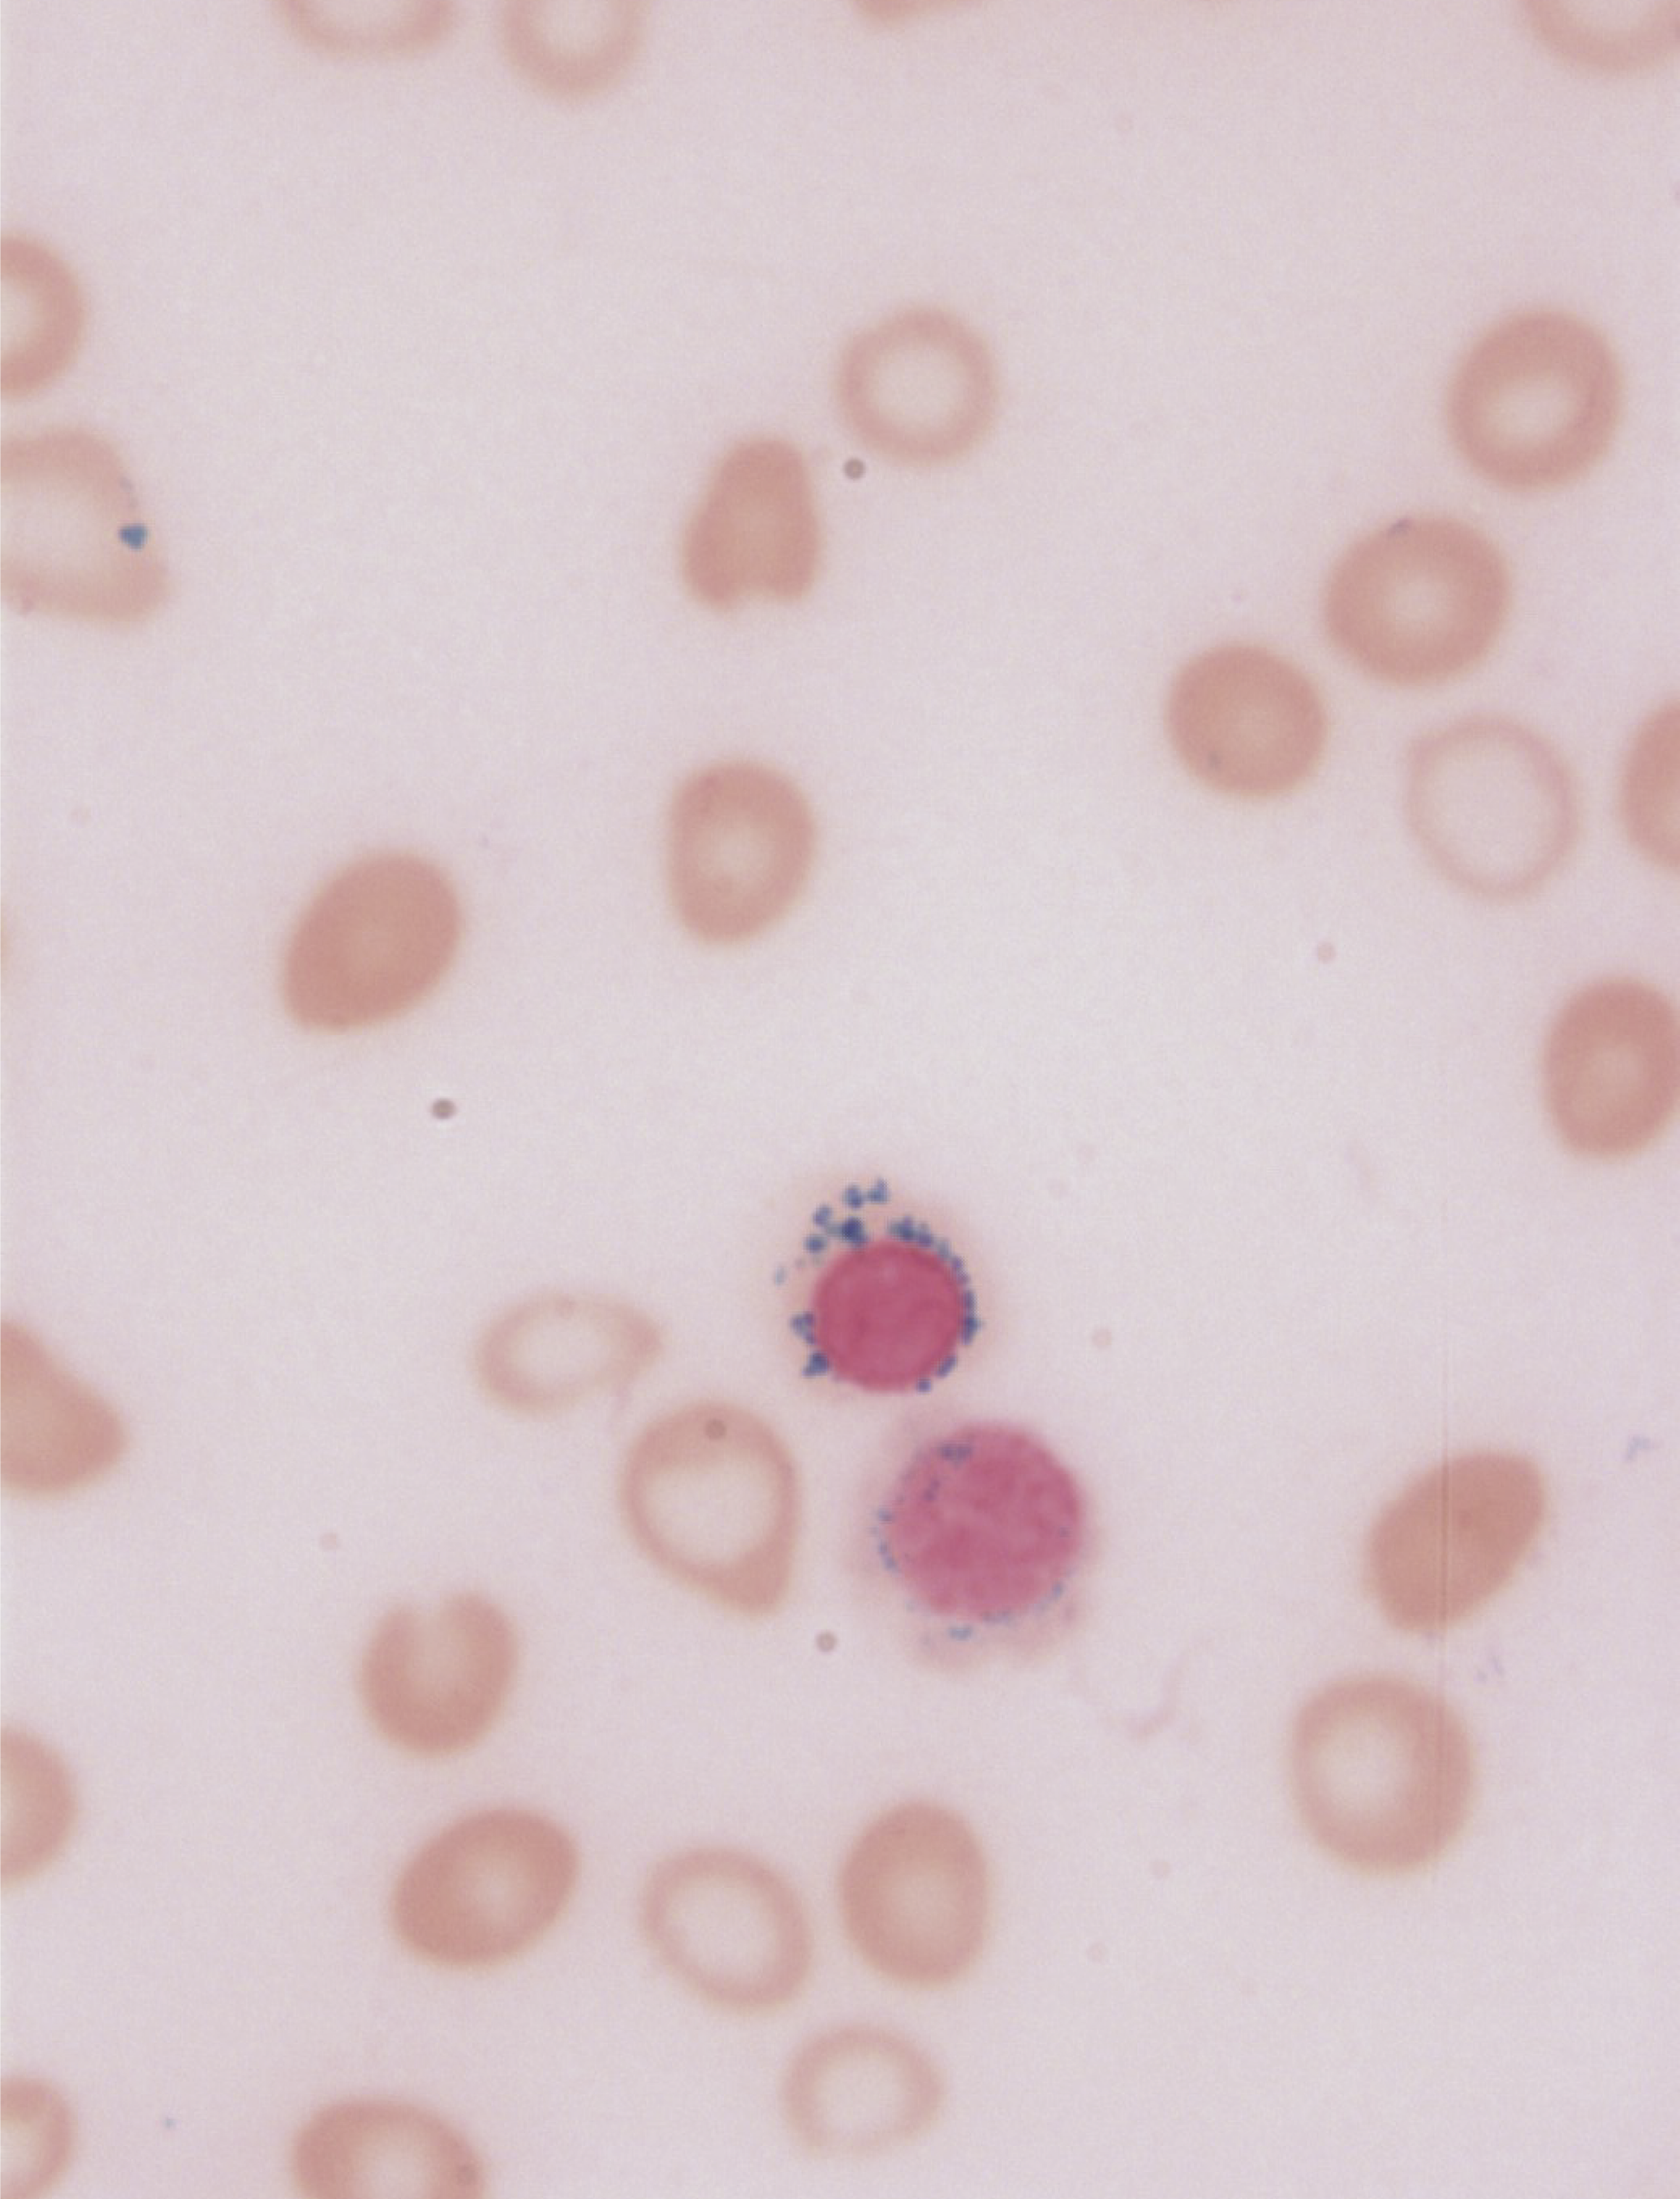

Issue Archive
Table of Contents
BLOOD COMMENTARIES
PERSPECTIVE
Targeting the tumor microenvironment for treating double-refractory chronic lymphocytic leukemia
With the advent of Bruton tyrosine kinase inhibitors and the BCL2 inhibitor venetoclax as targeted therapies now central to the management of patients with chronic lymphocytic leukemia (CLL), the greatest current challenge for physicians and patients is tackling CLL that is resistant to both classes of drugs. Lewis and colleagues provide their perspective on how we should address this increasing group of patients. After reviewing the pertinent literature, the authors highlight the importance of targeting the tumor microenvironment as part of the strategy to overcome dual-refractory leukemia. They advocate for programs that first diminish the proleukemic microenvironment before rebuilding and retaining an immune system that maintains remissions.
CLINICAL TRIALS AND OBSERVATIONS
Correlation of immune fitness with response to teclistamab in relapsed/refractory multiple myeloma in the MajesTEC-1 study
Clinical Trials & Observations
Teclistamab, a bispecific antibody targeting the plasma cell antigen B-cell maturation antigen (BCMA) and stimulating T cells via CD3, is approved for relapsed/refractory multiple myeloma. Cortes-Selva and colleagues report that while the level of expression of BCMA was not predictive of responses seen in a phase 1/2 trial, analysis of the relationship between baseline immune status and responses was informative. The baseline function of the immune T-cell repertoire in blood and myeloma sites predicts clinical responses, with durable responses associated with fewer exhausted or immunosuppressive T cells.
LYMPHOID NEOPLASIA
CAR T cells vs bispecific antibody as third- or later-line large B-cell lymphoma therapy: a meta-analysis
Clinical Trials & Observations
In the absence of clinical trials directly comparing chimeric antigen receptor (CAR) T-cell therapy and bispecific antibody therapy, Kim and colleagues report on a meta-analysis comparing their respective efficacy and safety for patients with relapsed/refractory large B-cell lymphoma in the third line and later. Pooled complete remission and progression-free survival rates appeared to be significantly higher for CAR T cells than for bispecific antibodies, but CAR T-cell therapy carried a greater risk of serious adverse events, including cytokine release syndrome, neurotoxicity, and infections. These analyses need to be interpreted with some caution given the inherent uncertainties of indirect comparisons but do highlight key challenges that need to be overcome with either modality.
MYELOID NEOPLASIA
BCR::ABL1 kinase N-lobe mutants confer moderate to high degrees of resistance to asciminib
Clinical Trials & Observations
Brief Report
Asciminib is the first approved in a new class of tyrosine kinase inhibitors (TKIs) that inhibit ABL signaling in chronic myeloid leukemia by inducing conformational change to an inactive configuration rather than by blocking the adenosine triphosphate binding site. Using cell viability assays, molecular simulations, and drug binding studies, Leyte-Vidal et al reveal how BCR::ABL1 N-lobe mutants, such as M244V, confer resistance to asciminib and can be observed in patients previously treated with imatinib. These data provide new insights into TKI resistance and have implications for resistance mutation testing prior to the use of asciminib.
PLATELETS AND THROMBOPOIESIS
Fostamatinib effectiveness and safety for immune thrombocytopenia in clinical practice
Clinical Trials & Observations
RED CELLS, IRON, AND ERYTHROPOIESIS
Mitochondrial tRNA pseudouridylation governs erythropoiesis
Clinical Trials & Observations
Mitochondrial myopathy, lactic acidosis, and sideroblastic anemia (MLASA) is an inherited anemia with broad clinical features that is associated with mutations in the gene pseudouridine synthase 1 (PUS1), which converts uridine to pseudouridine after it has been incorporated into RNA. Wang et al identified a novel frameshift mutation in PUS1 in a patient with MLASA and used patient-derived induced pluripotent stem cells and murine models to demonstrate that PUS1 loss impairs mitochondrial function and blocks erythroid differentiation. Impressively, mammalian target of rapamycin inhibition therapy appears to partially reverse the anemia in both the models and the patient.
LETTER TO BLOOD
Impact of hematopoietic cell transplantation on myocardial fibrosis in young patients with sickle cell disease
Clinical Trials & Observations
Patients with sickle cell disease (SCD) suffer from accelerated microvascular aging that in the heart manifests as fibrosis with increased left ventricular mass, diastolic dysfunction, pulmonary hypertension, and a propensity to arrhythmias and sudden death. Sharma and colleagues present magnetic resonance imaging evidence that hematopoietic stem cell transplant rapidly reverses biomarkers of cardiac fibrosis in young patients with SCD. These data also have implications for patients receiving disease-modifying therapies.
BLOOD WORK
-
Cover Image
Cover Image
![issue cover]()
Pathological iron accumulation in the mitochondria is shown in the bone marrow smear of a patient with mitochondrial myopathy, lactic acidosis, and sideroblastic anemia syndrome. See the article by Wang et al on page 657.
- PDF Icon Front MatterFront Matter
- PDF Icon Table of ContentsTable of Contents
- PDF Icon Editorial BoardEditorial Board
Advertisement intended for health care professionals
Email alerts
Advertisement intended for health care professionals